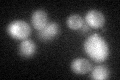
YKL195W

View description
Essential protein of the mitochondrial intermembrane space (IMS); promotes retention of newly imported proteins; may do so by stabilizing client protein folding as part of a disulfide relay system or transferring metal to client proteins
Localization:
Intensity:
Fold change:
Significance:
-
C’ GFP library in SD

below threshold16.18 -
N' NOP1pr-GFP in SD

mitochondria96.0036 -
N' TEF2pr-mCherry in SD

mitochondriaN/A -
N' NATIVEpr-GFP in SD

missing0 -
N' TEF2pr-VC and Cyto-VN in SD

#N/A0 -
C’ GFP library in SD+DTT
cytosol16.311No -
C’ GFP library in SD+H2O2

cytosol17.661.09No -
C’ GFP library in Starvation Media

cytosol15.50.95No -
C’ GFP library on the background of Pup2-DaMP

below threshold -
C’ GFP library on the background of CCT mutant

below threshold16.79891.03791No
